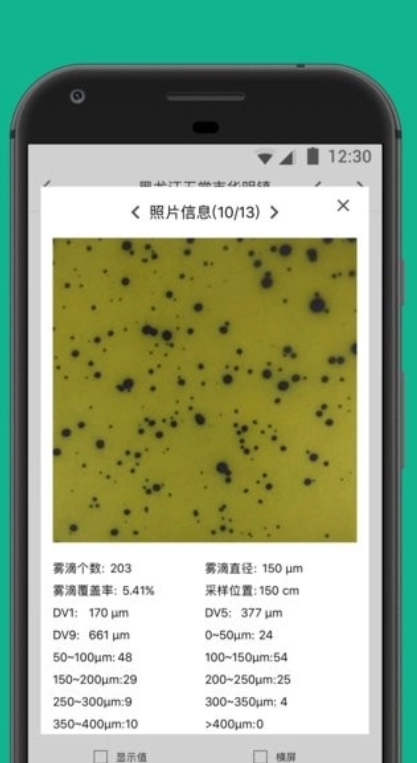
为农宝截图0

为农宝,这里每天都会更新海量农业新闻资讯与相关政策信息,用户可直接在此搜索所需内容,平台还涵盖美化工具、搜索工具、桌面工具、手机助手等实用功能。其软件功能十分全面,能助力用户所在村庄提升先进的农产品种植技术;并且每日都会推送最新农业新闻资讯,用户可从中获取最新农产品信息,是一款能切实帮助用户学习进步的软件。
第一时间掌握最新的乡村资讯,为你推荐农户资源供了解,助你学习最新的种植技术。
可以直接在这里看到大量农业相关信息,还有不少多元化服务也能直接在这里办理。
各类信息资源清晰呈现,打造优质且全面的乡村建设服务就由此起步,助力每家每户提高自身的产值。

这款软件功能十分强大,用户能够借助它学习农业种植知识,软件里还配备了专业讲师提供在线指导。
用户能够接触到各类前沿的育种技术以及丰富多样的学习资源。若您在养殖过程中遇到任何疑问,都可以向专业专家寻求帮助,他们会为您答疑解惑。

有很多政策信息可以直接在软件里了解到,各类相关的政府补贴也能及时知晓!
能够直接查看农业信息,多种农业相关服务实时提供!
获取最新的乡村资讯,助你掌握前沿的种植技术。
各类信息资源清晰明了,助力家家户户提高自身的产值。
这里提供全面的农业相关信息,您可直接在此搜索所需的内容。
内容简洁实用,为大家提供更多专业农业知识,助力用户更好地学习。
每天都能获取最新的农业新闻资讯,在这里还能掌握更多市场行情与行业动态。
这是一款能助力农民学习先进种植技术的软件,用户通过手机就能参与村民共富实践。
在这里能够获取最新的农产品资讯,同时也有丰富的农业技术可供学习。
并且还能在软件里找到共同致富的办法,也可以随时知晓其他村子的发展状况,助力乡村振兴,确实挺好的,有需要的朋友赶紧行动起来吧。
可以直接在这里看到大量农业相关信息,还有丰富的多元化服务也都能直接在这里办理。
第一时间为你推送最新的乡村资讯,还有精选的农户资源供你了解,助你掌握前沿的种植技术。
各类信息资源清晰呈现,构建优质且全方位的乡村建设服务便由此起步,助力每一户家庭提高自身的产值。
第一时间为你推送最新的乡村资讯,还会推荐农户资源供你了解,助你掌握前沿的种植技术。
可以直接在这里看到大量农业相关信息,还有不少多元化服务也能直接在这里开展。
各类信息资源清晰呈现,打造优质且全面的乡村建设服务就由此起步,助力每家每户提高自身的产值。
这是一款能够帮助农民朋友们轻松学习先进种植技术的软件,用户可以直接在手机上参与村民共富项目。
在软件里能找到共同致富的办法,还能随时知晓其他村子的发展状况,助力乡村振兴,确实挺好。
还有大量信息资源可供随时了解,能满足更多乡村振兴体验需求,助力打造更完善的乡村建设。
每天平台都会更新海量农业新闻资讯与相关政策信息,在这里,小伙伴们还能借助种植百科查询并学习各类农产品的种植技巧,运用科学高效的种植方法提升农产品的产量与品质。
内容简洁实用,为大家提供更多专业农业知识,助力用户更好地学习。
这里提供全面的农业相关信息,您可以直接在此搜索所需的内容。
每天都能获取到最新的农业新闻资讯,市场行情和行业动态等丰富内容都可以在这里一手掌握。
在软件里探寻共同致富的路径,还能随时知晓其他村子的发展动态,助力乡村振兴,确实挺好。
第一时间获取最新乡村资讯,为你推荐农户资源供了解,助你学习最新种植技术。
各类信息资源清晰呈现,打造优质且全面的乡村建设服务就由此起步,助力每家每户提高自身的产值。
软件中的功能十分全面,能够助力用户所在的村庄实现先进农产品种植技术的提升。
用户可在本软件中查看各类优质的政策信息,让大家能放心使用。
软件里的所有功能都对用户免费开放,是一款能切实助力学习提升的软件。
8.9分

《此间山海》是一款以东方幻想为题材的大型多人在线角色扮演游戏。在这片广阔而神秘的异世界里,玩家将开启一段奇遇不断的冒险之旅。游戏构建了一个多种族和谐共存的幻想大陆,巧妙融合了《山海经》的经典元素与古典美学风格,玩家将在探索中逐步揭开隐藏在这个世界背后的层层秘密。

银河壁纸免费版是一款能提供精美壁纸的手机应用,静态、动态壁纸种类齐全,还具备个性彩铃功能,打造主题壁纸十分轻松,并且支持自定义壁纸,让手机时刻保持新鲜感与个性化,使用户在使用过程中享受极致的视觉体验。

小跃跃跑腿是依托移动互联网搭建的本地服务平台,主要为用户提供快递代取、代寄的上门服务。用户可随时查看个人订单,平台会将丰富的订单信息推送给跑腿人员以便接单处理。用户下单后,快递、外卖等业务的效率得到显著提升,从而为用户带来优质的服务体验。

《违章查询》支持全国交通违章查询服务,全程干扰,查询覆盖北京、广州、上海等30多个省市,包含汽车违章、交通违章、违章车辆等各类查询功能,还提供车辆违章推送服务,欢迎前来体验!

欢快走是一款通过走路赚取零花钱的软件,步数可以兑换收益。这里为你推荐的是一款非常不错的走路赚钱应用,让你在快乐行走的同时轻松获取更多佣金,还能自由体验独特的运动过程。用户通过该软件能实时记录每日运动情况,可谓一举两得。

疯狂的大厨,《疯狂大厨》是一款能让你体验经营餐厅乐趣的美食休闲游戏,极高的可玩性与解压体验让众多玩家沉浸其中,享受每一步操作带来的乐趣。在这里,你可以开启一场真实的厨师大亨冒险,感受沉浸式的烹饪体验,还能自由搭配食材、创造独特美食,营造欢乐的美食氛围。如果你也对这样的游戏感兴趣,不妨来试试吧!

魔秀壁纸免费版是一款备受欢迎的手机壁纸应用,每日推送最新、最热门的壁纸资源,一键即可使用且流量消耗低。软件内包含海量优质壁纸与主题资源,影视剧、美女、动漫、电影等各类壁纸一应俱全,能让你的手机更具个性。此外,其高自由度的桌面编辑功能还可助你打造专属桌面。

七毛免费漫画最新版是一款助力用户轻松阅读各类精品漫画的应用,通过关键词一键检索即可迅速定位心仪漫画,平台涵盖的漫画类型极为丰富,全程无需会员与任何费用,热门榜单为你提供优质阅读指引,海量新漫画实时更新,多元阅读模式营造舒适阅读氛围,想要获取更多漫画资源,就来12365网下载七毛免费漫画最新版吧!

手机录屏大师允许玩家自由录屏,能稳定捕捉各类手机画面,录屏效率颇为出色,功能丰富,支持文件导入导出,可助力用户轻松录制高清屏幕视频,有需求的用户不妨体验。

棉花公寓是一款便捷的掌上租房软件,可根据用户需求自动匹配对应地区的公寓及待租房源,提供多种房型与丰富房源供用户自由选择,帮助用户获取更多房源信息。平台无中介收费,还提供多种看房方式,助力用户租到心仪好房,欢迎大家体验棉花公寓!

大厨美食店是一款模拟经营类手机游戏,玩家将化身为餐厅老板,从装饰餐厅、采购食材到烹饪美食,一步步打造属于自己的餐饮帝国。游戏融合了经营策略与趣味挑战,玩家需要吸引顾客、提升菜品品质,并巧妙应对各种经营难题。丰富的食材选择和多样的食谱设计,让这款游戏充满创意,十分有趣,快来体验吧!

皮皮漫画最新版是一款拥有海量精品漫画的免费阅读软件,它不仅会推荐热门漫画资源,而且不管你偏好哪种类型的漫画,所有资源都能免费畅读。软件提供多种阅读模式,让你能安心流畅地加载更多漫画,每天还会持续更新内容,带来优质的阅读体验。想阅读更多漫画的话,就来12365网下载皮皮漫画最新版吧!

植物星球是一款线上购物软件,涵盖家居用品等各类商品。用户可参与正在进行的活动,还能免费领取并使用多种优惠券。此外,用户可以对喜欢的视频进行点赞、分享和评论,从而享受优质的购物服务体验。

《灯塔之光》是一款深受玩家欢迎的手机游戏。在遥远的海域上,矗立着一座古老的灯塔,它的光芒是对抗黑暗的唯一依靠。玩家在游戏里化身为一名守望者,承担起守护这座灯塔的使命,凭借智慧与勇气驱散黑暗,净化被黑暗污染的海怪,维护这片海域的安宁与祥和。感兴趣的朋友赶紧行动起来吧!

米加小镇派对手机版,是一款趣味满满的模拟养成类手游。游戏操作十分简单,融入了多种互动元素,让整体可玩性大幅提升。采用可爱的卡通画风,男女老少都能轻松上手。还有超多NPC等待你的互动,玩法全由你决定!感兴趣的话,就快来体验吧!

《第一棵树》是一款备受玩家青睐的治愈系单机冒险探索游戏。在游戏里,玩家会慢慢揭开记忆碎片里藏着的秘密,收获触动人心的情感体验。随着游戏进程,玩家能体会到生命中的酸甜苦辣,最终走向满是希望与勇气的结局。

超级坦克对战游戏是以坦克作为核心作战单位的游戏,玩家既可以参与多人在线对战,也能体验单人闯关射击模式。在游戏中,玩家需要操控不同类型的坦克,在战场上与敌人展开紧张刺激的较量。游戏背景设定十分多样,涵盖现代战争、未来科幻、二战时期等不同风格,为玩家带来丰富多元的游戏体验。感兴趣的朋友不要错过,快来加入吧!

劲乐幻想手机版是由腾讯重磅推出的一款次世代音乐主题换装社交手游,由《劲乐团》、《劲舞团》原班人马倾情打造,承载着无数玩家的青春回忆与音乐梦想。玩家将扮演自由音乐人身份进入世界音乐中心赤岛,在这里结识志同道合的伙伴、组建专属乐队、开启一段热血沸腾的劲乐旅程。游戏创新性地融合了乐队演奏、自由换装、社交互动、剧情养成等多元玩法,突破了传统音乐游戏的单一框架。海量曲库涵盖流行、摇滚、电子、中国风等多种风格,从怀旧经典到抖音热歌应有尽有,搭配炫酷的3D乐器与精致的角色造型,为玩家呈现极致的视听盛宴。支持Android、iOS及PC多端互通,随时与好友一起合奏演出、制作专属MV,感受音乐与社交的完美融合。

冰火之家是一款专注于旅游住宿的软件,这样一款处处为出行者着想的应用,怎能不让人心动呢?它能帮助平台用户在户外出行时第一时间找到价格实惠、安全可靠且干净整洁的住宿房间。依托六大智能系统,用户还能感受到当地人的热情款待,无论是华东、华南还是西南等地区,都能为旅游出行提供便捷的服务。

会说话的猫猫是一款治愈系模拟养成游戏,玩家能和一只可爱的会说话的猫咪互动,通过喂食、抚摸、玩耍等方式增进好感,解锁更多趣味对话与表情。还可以布置温馨房间、为猫猫更换不同服饰、探索多样场景,体验轻松愉快的养成乐趣,是款不错的养成手游,快来试试吧。

众所周知,生辰时钟不仅能帮你记录生日信息,还能记录已经过去的时间和未来剩余的时间,让你清晰认识到时间的珍贵。软件功能丰富、用法多样,使用起来十分方便,能让你尽情体验各种乐趣。

老乡洗个澡是一款轻松幽默的闯关小游戏。玩家需要帮助“老乡”完成洗澡任务,通过滑动、点击等简单操作,避开各种搞笑障碍,顺利让老乡完成洗澡。游戏关卡设计充满创意,每个关卡都有独特的场景和挑战,玩家需要灵活应对各种突发情况,解锁更多有趣的隐藏内容,快来挑战吧!

肚皮弹射是一款精彩的休闲益智游戏,游戏内设有丰富的成就与任务,完成这些可以解锁特殊技能和奖励;还有多样化的服装组合,让你能展现独特的个性化风格;使用道具可以提升角色的机动性,帮助你巧妙避开各种障碍物。对这款游戏感兴趣的话,就快来体验吧!

啵乐漫画正版是一款十分优质的手机漫画阅读软件,平台内拥有海量免费资源,操作便捷高效,点击即可快速加载阅读,让用户轻松获取更多高品质漫画内容。所有漫画均提供高清完整的阅读体验,新品资源也会持续更新,感兴趣的用户不妨前来体验一番。

图灵自动点击器免费版是一款提供手机免费连点功能的软件,可真实模拟人工点击操作,还支持自动设置时间,一键即可启用;能轻松存储和加载各类手机点击任务,自由切换配置开启自动连点,完全满足大家的手机自动点击需求,支持定时、多开等任务模式选择,对手机配置要求不高,想要体验更多连点功能,就来12365网下载图灵自动点击器免费版吧!

开罗风格的滑雪模拟游戏《闪耀滑雪场物语》,以复古像素画风为玩家带来别样趣味体验。游戏中不仅能欣赏到无数雪中美景,还需要玩家运用合理的经营策略,展现出色的经商才能。通过研发更多新设施供玩家灵活使用,持续为大家带来更丰富的玩法乐趣。

《狙击最强者》是一款刺激的射击挑战游戏。在游戏里,你可以借助扫描道具,细致地勘察场景的各个角落,去搜寻那些伪装起来的外星生物。游戏采用经典的射击玩法,你需要在不同的环境中找到并狙击这些隐藏的外星生物。要是你感兴趣,就快来体验一番吧!

电工专家手机版,内容按电工资料、计算、试题和电路图分类,涵盖变压器等资料,并且该版本已解除应用使用限制。它专注于电工技术与技能,汇集了海量知识点,所有资料均可查看。

八门神器所有版本,如同一个庞大的“游戏辅助军团”。有经典的老版本如v2.60,操作简单易上手。也有免root版,无需root权限就能修改游戏数据。还有最新的v4.0.2.1版本,功能更强大,界面更优化。此外,像手机版、电脑版、社区app版等不同类型版本,为玩家提供修改游戏、下载游戏、交流互动等全方位服务。心动的小伙伴们,快来下载试试看吧!

堡垒之夜的各种版本,宛如一群充满创意的游戏精灵,为玩家带来多元的游戏盛宴。有主打大逃杀的经典版,百人同场竞技乐趣无穷。合作防御的拯救世界版,可与队友携手对抗丧尸。还有能自由创造的创意版,任你打造专属世界。更有乐高版、赛车版、节奏版等带来别样体验,各版本都以独特玩法,邀你沉浸在堡垒之夜的奇妙世界。

玩家可以制作寿司的游戏好玩在哪?这类游戏模拟寿司制作过程,让玩家体验美食制作乐趣。从挑选食材,如新鲜鱼肉、米饭等,到切割、包裹、造型,每个步骤都细致呈现。游戏提供丰富食材与制作工具,玩家发挥创意,制作独特寿司。完成制作后,还可能有顾客品尝、评价环节,获得收益解锁新食材与场景。轻松休闲玩法,搭配精美食材画面,带来愉悦视觉与操作体验,满足美食制作与经营爱好。

壁纸个性化手机APP大全,堪称专为渴望独特视觉体验的手机用户精心打造的宝藏之地。在这里,海量高清且创意满满的壁纸资源汇聚一堂,无论是抽象艺术、自然风光,还是动漫角色、明星偶像等各类风格,一应俱全。用户不仅能够便捷地寻找到契合自身个性的壁纸,还能借助强大的编辑工具,定制专属于自己的壁纸,使手机屏幕摇身一变,成为展现个人风格的独特窗口,每天都能收获新鲜感与惊喜。

小编用心整理了一系列以正太为主角的游戏,覆盖多种游戏类型。精选了12至16岁主角的经典作品与全新力作,让玩家能和一群Q萌软萌的正太伙伴们共同踏上冒险旅程,感受多样的游戏乐趣。我们从角色设计(包括服饰搭配与表情细节)、故事叙事的纯粹度、玩法与操作的适配性(如操作简化优化)这三个维度进行严格筛选,还独家收录了导演剪辑版本,其中新增了数小时的隐藏剧情内容。喜爱正太题材游戏的玩家,不妨收藏这个合集页面,从中挑选心仪的游戏下载体验吧!

pubgtool画质助手是一款专为喜爱吃鸡游戏的用户打造的辅助工具,能有效帮助玩家调整游戏内的画质清晰度。提升画质后,玩家可凭借出色的射击技术更顺利地完成击杀,该软件支持一键解锁极限帧率、开启SG优化等功能,让你能自由设置游戏画质参数。

碎片时间想追短小精悍的热门短剧?免费短剧追剧软件合集专题提供了海量热门短剧资源,涵盖都市、悬疑、甜宠等各类题材,支持离线缓存、倍速播放,更新速度快,让你在碎片时间就能看完一个完整剧情,满足你的追剧需求。喜欢这类的朋友,不要错过!

想要通过语音指令轻松完成各种任务?支持智能语音交互的AI助手推荐专题为你带来便捷体验。这些应用集成了先进的语音识别和自然语言处理技术,能够理解你的语音指令,完成信息查询、日程管理、设备控制、聊天对话等多种功能。界面设计简洁,响应迅速,支持个性化设置。无论是提高工作效率,还是寻求娱乐陪伴,都能提供贴心的帮助。立即下载,体验智能科技带来的便利生活。

敢不敢挑战心跳加速的惊悚体验?这类生存恐怖游戏主打黑暗压抑的氛围,你需要在危机四伏的场景里寻找线索、躲避怪物,有些还需要收集资源生存,每一步都充满未知的恐惧,解谜+逃生的双重刺激,能让你体验到肾上腺素飙升的快感,喜欢惊悚感的玩家千万别错过!

向往在荒野里靠双手活下去?硬核生存游戏能满足你的冒险欲!这类游戏主打资源收集、建造基地、抵御危险,你需要面对饥饿、寒冷、怪物等多重挑战,部分支持多人联机协作,每一次存活都是胜利,能让你体验到原始生存的刺激感,喜欢挑战的玩家快来试试!

本专题集合《火影战记》的各类衍生版本,包含满人物解锁、博人传新角色、怀旧老版本等,你能操控经典火影角色展开热血格斗,释放专属忍术,体验轻量版忍界对战的乐趣,快来开启你的火影格斗之旅!

专题收录各类趣味解压休闲手游,包含收纳整理、物理破坏、互动解压等多样玩法,操作简单易上手,能有效释放日常压力、舒缓情绪,随时随地都能开启治愈放松的体验,快来试试吧!

这是一款主打解压的动作格斗系列游戏,玩家操控角色在不同场景中狂扁对手,释放生活压力。全系列包含无敌版、双人合作版,玩法简单粗暴,打击感十足,适合在碎片时间放松心情,体验拳拳到肉的解压乐趣,快来加入狂扁小朋友的格斗战场!

围绕中式民俗设定展开的悬疑解谜玩法,在古宅、村庄等场景中收集线索,破解民俗相关谜题,揭开故事背后的隐秘真相。拥有阴森恐怖的氛围与环环相扣的剧情,挑战你的推理能力与胆量!

主打休闲模拟经营玩法,玩家可经营餐厅、农场、浴场等场景,体验日常经营、角色养成、资源管理的乐趣,不同游戏覆盖古风仙侠、现代都市、田园农场等题材,沉浸于慢节奏的经营氛围中,缓解日常压力。

想找无广告的背单词工具却找不到适配的炭炭背单词版本?炭炭背单词全版本合集提供了纯净版、官方版、官网版等多个选择,采用艾宾浩斯遗忘曲线算法,支持自定义单词本、离线背单词,纯净版无广告无冗余功能,界面简洁操作简单,大幅提升英语单词记忆效率。喜欢的小伙伴们不要犹豫了,快来下载试试吧!

想找全能的手机工具盒子?熊盒子全版本合集专题提供了熊盒子的多个专属版本,包括app版、白鸽软件版、官网版等,聚合多种实用工具,支持系统优化、资源搜索、工具管理,操作简单高效,帮你一站式解决手机使用需求。喜欢这类的朋友,不要错过。

找不到无广告的漫蛙漫画版本?漫蛙漫画版本合集专题提供了这款热门漫画软件的多个适配版本。无论你需要无广告干扰的纯净版、解锁全内容的正版、适配新功能的最新版,还是习惯经典界面的旧版,都能在这里找到。它涵盖热血、少女、原耽等各类热门漫画,支持下拉式阅读、离线缓存、追更提醒,是漫画爱好者的追番利器。有需求的朋友们快来下载试试看吧!

治愈系小动物模拟游戏推荐,包含鳄鱼洗澡、小黄人跑酷、猫咪城市、小偷猫养成等玩法,内置趣味剧情,解锁动物专属技能与皮肤,治愈日常疲惫,还能和小动物互动解锁专属剧情,收集稀有道具装扮家园。

想要提升外语水平或快速翻译外文内容?外语学习与专业翻译软件合集专题提供了多款专业的学习和翻译工具。它们支持多语言互译、单词记忆、口语练习等功能,能帮你打破语言壁垒,无论是日常学习还是出国旅行,都能提供高效的语言支持,提升外语能力。感兴趣的话,就来下载试试看吧!

想养成规律的健康生活习惯?日常习惯与健康管理软件合集专题提供了涵盖步数记录、饮食打卡、减脂规划等多功能的习惯养成工具,帮你规律生活作息,提升健康水平,打造个性化的健康生活方式,满足各类用户的日常习惯管理需求。立即下载,开启你的健康生活之旅。

本专题汇聚模拟经营类治愈手游,玩家将经营各类店铺与场所,从店长到商业大亨,体验轻松治愈的经营乐趣,解锁暖心剧情与特色装饰,释放日常压力,快来开启你的经营致富之旅!

想玩最新版体验末日更新的生存挑战,或是冲无限货币版随便买物资、建基地?甚至玩完整版解锁所有剧情、地图?活下去全版本合集满足你的末日生存欲!在丧尸横行的世界里找食物、造武器、建基地,每一个选择都关乎生死,末日生存爱好者快来挑战你的生存极限~

聚焦三国题材的策略SLG游戏,玩家将化身乱世中的一方诸侯,通过招兵买马、建设城池、培养顶尖武将等方式壮大势力。游戏融入真实的三国历史背景与权谋博弈机制,玩家可自由制定对战策略,与其他玩家展开激烈的城池争夺与大军对决,体验磅礴的三国乱世纷争,开启专属的霸业征途。

对于有虚拟定位需求的用户,FakeLocation是一款常用的位置模拟工具。它可以帮助你在社交、游戏或打卡等应用中修改手机的地理位置。不同版本在定位精度、防检测能力和易用性上可能有所不同。这里汇集了它以及同类工具的多个版本,你可以根据具体应用场景选择最合适的一款。一站式满足你的位置模拟需求,操作便捷。有需求的朋友们快来下载试试看吧!

在寻找恐怖冰淇淋的所有版本?这个专题对于恐怖游戏爱好者而言意义非凡。恐怖冰淇淋系列以其紧张的氛围、诡异的罗德先生和需要智取的逃生玩法,带来持续的惊悚体验。不同版本对应着系列的不同章节,从1代到9代,故事层层递进,谜题和场景不断更新。部分版本还提供了如无限子弹、内置菜单等特殊模式,让玩家可以以不同的方式应对恐惧。这里汇集了该系列几乎全部的主要版本及特色改版,让你可以一口气体验完整的惊悚之旅。胆大的你快来挑战吧!

火影忍者题材游戏精选汇集火影女忍者训练师、火影忍者异族崛起、火影不解之缘、火影忍者替身计时器、火影忍者亿忍集结、火影忍者最后的战争、火影之异族崛起、火影忍者云游戏等多款动漫改编作品,玩家可扮演火影忍者角色,体验忍术战斗、剧情冒险等玩法,火影迷不可错过。

《异常咖啡机2》各版本,为你带来一段离奇又充满谜题的冒险。这款游戏通常以其独特的设定和烧脑的解谜环节吸引玩家,你需要操作一台“异常”的咖啡机,揭开背后的秘密。游戏体验充满意外和探索的乐趣。这里汇集了它的几个版本,包括内容完整的标准版和可能包含额外内容的豪华版,不同版本在故事体验或附加要素上可能各有侧重。免去四处搜寻的麻烦,直接沉浸在这个古怪而有趣的世界里。解谜爱好者们,快来挑战吧!